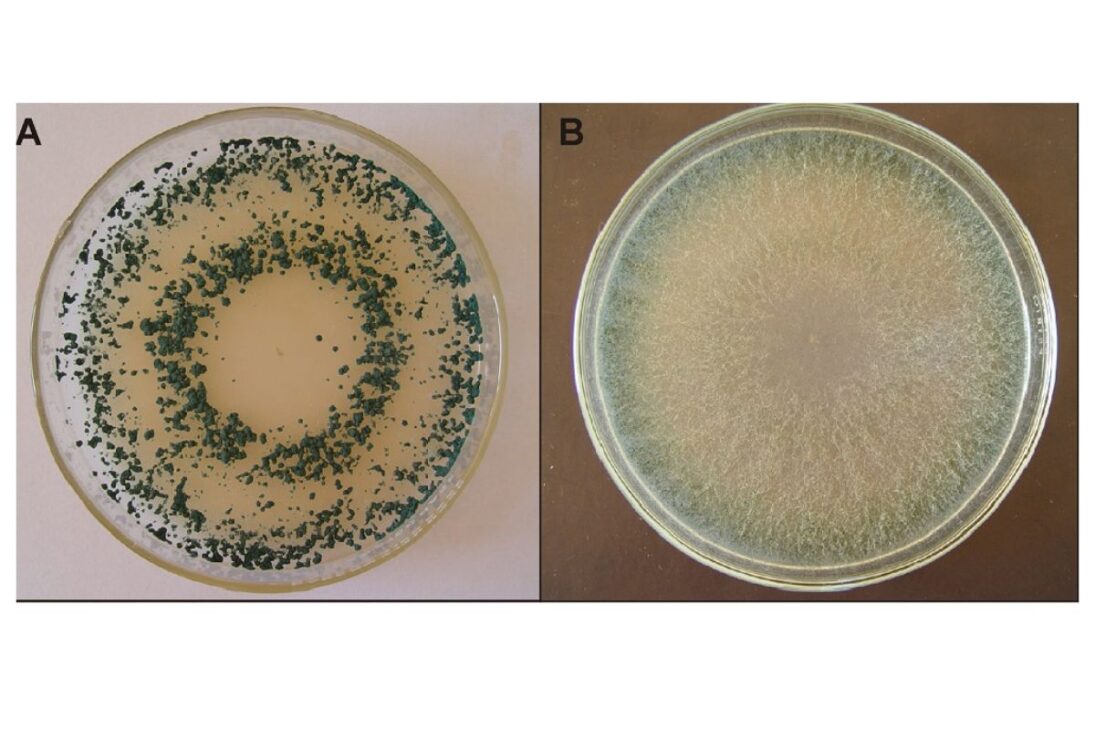

El hongo Trichoderma agriamazonicum, identificado en la Amazonía por investigadores de Embrapa, combina control biológico de plagas, producción de compuestos inéditos y actividad antimicrobiana contra bacterias asociadas a la neumonía, con resultados in vitro prometedores para la agricultura sostenible y un posible desarrollo de bioproductos que reduzcan la dependencia de agroquímicos y antibióticos en Brasil.
El hongo Trichoderma agriamazonicum ha entrado en el radar de la investigación brasileña como un descubrimiento con doble frente de interés: proteger plantas en sistemas agrícolas y proporcionar moléculas bioactivas con potencial de aplicación médica. Encontrado en la Amazonía y estudiado en profundidad por Embrapa Amazonía Occidental, se observa como un candidato estratégico para bioproductos.
La atención sobre esta especie ha crecido porque los resultados reunidos hasta aquí no apuntan a un único efecto aislado, sino a un conjunto de capacidades técnicas: control de fitopatógenos, producción de péptidos inéditos y acción contra bacterias relacionadas a la neumonía. Es precisamente esta convergencia entre campo y laboratorio la que transforma el descubrimiento en un tema central para la agricultura y la biotecnología.
De la recolección en la Amazonía al reconocimiento de una nueva especie

El Trichoderma agriamazonicum fue identificado a partir de muestras recolectadas en una especie maderable nativa amazónica, dentro de una línea de investigación enfocada en microbiología aplicada.
-
Com 25 mil toneladas, 144 metros de longitud y un contrapeso de 1.750 toneladas, China gira un puente entero en 80 minutos con precisión milimétrica monitorada por satélite.
-
Científicos descubren 85 lagos escondidos bajo kilómetros de hielo en la Antártida, elevan a 231 el número de reservorios activos y revelan un sistema de agua líquida funcionando en la oscuridad bajo el continente congelado.
-
Olvídate del guardarraíl común: las carreteras solares comienzan a ganar barreras con paneles ultrafinos en Europa, capaces de generar energía limpia, abastecer iluminación, señalización y túneles sin ocupar nuevas áreas y transformar carreteras en plantas discretas a lo largo de miles de kilómetros.
-
Alemania prepara la mayor batería de Europa con 4 GWh, un proyecto gigante de LEAG y Fluence que promete almacenar energía renovable, estabilizar la red eléctrica y transformar una antigua región del carbón en un escaparate de la transición energética.
El trabajo fue realizado por Thiago Fernandes Sousa y Gilvan Ferreira da Silva, con identificación en 2023 y un análisis profundo en los años siguientes, incluyendo datos consolidados en una tesis defendida en 2025.
El nombre de la especie no fue elegido al azar: «agriamazonicum» conecta origen territorial y vocación de uso. Al pertenecer al género Trichoderma, conocido por su historial en control biológico, este hongo ya forma parte de una base científica relevante.
La diferencia aparece cuando los datos morfológicos y filogenéticos muestran características genéticas propias, sustentando formalmente la proposición como nueva especie y ampliando el abanico de aplicaciones posibles.
Control biológico de plagas con mecanismos combinados
En el ambiente agrícola, las pruebas in vitro indicaron la eficiencia del hongo contra nueve especies diferentes de fitopatógenos. Este número llama la atención porque señala una actuación amplia, no limitada a un único agente de enfermedad. En términos prácticos, cuanto mayor sea la amplitud, mayor será el interés por futuras formulaciones biológicas para diferentes cadenas productivas.
La inhibición observada ocurrió por al menos dos mecanismos centrales: micoparasitismo y producción de compuestos orgánicos volátiles. En términos simples, esto significa que el microorganismo no depende de una única ruta de acción para contener al patógeno.
Entre los objetivos destacados están Corynespora cassiicola y Colletotrichum spp., que afectan cultivos como la soja y frutas. Esta actuación multifactorial es técnicamente valiosa porque reduce la dependencia de respuestas únicas en escenarios de alta presión de enfermedades.
Compuestos inéditos y la «fábrica química» del genoma
Uno de los puntos más fuertes de la investigación está en la minería genómica de los BGCs, los agrupamientos de genes biosintéticos. Estos conjuntos funcionan como módulos capaces de orientar la producción de moléculas de interés, incluyendo para defensa e interacción ambiental. En el caso del Trichoderma agriamazonicum, el análisis de estos bloques reveló la posibilidad de compuestos aún no descritos.
A partir de ahí, se aplicó una estrategia bioinformática con el algoritmo PARAS, utilizado para predecir la secuencia de aminoácidos de peptaibols antes del aislamiento clásico.
En la etapa siguiente, los compuestos previstos fueron sintetizados químicamente por un enfoque llamado syn-BNP (productos naturales bioinformáticos sintéticos).
La ventaja de este camino es acelerar el descubrimiento de moléculas bioactivas, reduciendo etapas largas de cultivo extensivo y purificación tradicional, sin renunciar a la precisión en la cribado inicial.
Cuando el mismo hongo cruza la frontera entre agricultura y medicina
Los peptaibols ligados al genoma del Trichoderma agriamazonicum mostraron actividad antimicrobiana comparable y, en algunos escenarios experimentales, superior a la de antibióticos comerciales.
En ensayos controlados, un peptaibol de 18 aminoácidos, sintetizado con base en predicción genómica, presentó acción contra Streptococcus sp. y Klebsiella pneumoniae, bacterias relacionadas con infecciones como neumonía.
Este resultado no transforma automáticamente la molécula en un medicamento listo, pero reposiciona al hongo como una fuente prometedora para un pipeline de innovación farmacéutica.
El punto técnico decisivo es que la misma especie que actúa en el biocontrol agrícola también entrega señales robustas para la investigación antimicrobiana, algo raro en descubrimientos iniciales.
En paralelo, el mismo peptaibol de 18 aminoácidos también mostró eficiencia antifúngica contra Pseudopestalotiopsis sp., asociado a la mancha foliar en guaraná, reforzando la utilidad dual del sistema.
Crecimiento vegetal: avance concreto, sin simplificaciones
En el eje de promoción de crecimiento vegetal, una cepa del Trichoderma agriamazonicum registró producción de 60,53 µg/mL de AIA (ácido indolacético), fitohormona importante para el desarrollo de plantas. El dato posiciona este aislado entre los de mayor producción de AIA testada en el conjunto experimental y ayuda a explicar el interés agronómico por la especie.
Al mismo tiempo, las pruebas en invernadero con pimiento mostraron que esta alta producción de AIA no se convirtió, de forma significativa, en un rendimiento superior al control negativo. Lejos de desvalorizar el resultado, esto aclara un punto esencial: la promoción de crecimiento vegetal es un fenómeno multifactorial, y un único marcador bioquímico no garantiza ganancia agronómica en todas las condiciones.
Este recorte refuerza la lectura científica más sólida: el principal valor del hongo puede estar menos en una promesa universal y más en aplicaciones específicas, con la formulación y el contexto correctos.
Lo que este descubrimiento puede cambiar en la práctica
Para la agricultura, el escenario más plausible es el avance de bioproductos capaces de integrar manejo sostenible, con potencial de reducir la dependencia de agroquímicos en determinados sistemas y cultivos.
Esto no significa una sustitución total e inmediata, pero abre camino a estrategias combinadas de control, especialmente en programas que ya incorporan bioinsumos y monitoreo fitosanitario.
Para la salud y la biotecnología, la ganancia está en la apertura de nuevas rutas de prospección de moléculas antimicrobianas en un momento en que la búsqueda de alternativas terapéuticas es urgente.
Cuando una especie recién descrita entrega compuestos inéditos y actividad consistente en laboratorio, deja de ser solo una curiosidad científica y pasa a ser un activo estratégico de investigación aplicada. La pregunta que emerge no es si hay potencial, sino cómo transformar ese potencial en tecnología validada, segura y escalable.
El Trichoderma agriamazonicum coloca al hongo amazónico en el centro de una agenda que une producción agrícola, innovación industrial e investigación antimicrobiana.
Los datos disponibles sustentan una conclusión equilibrada: hay señales fuertes de utilidad práctica, con resultados técnicos relevantes, y también hay límites claros que exigen validación continua en diferentes condiciones experimentales y productivas.
Ahora quiero escuchar tu opinión en redes: en tu realidad, ¿cuál problema pesa más hoy, enfermedad fúngica en los cultivos o resistencia bacteriana en la salud? Y, pensando a corto plazo, ¿confiarías en bioinsumos a base de hongo para reducir químicos en el campo, o crees que la transición aún está lejana?

O Brasil tem recursos inesgotáveis, basta incentivos governamentais, tais como Embrapa, para explorar infindáveis produtos que dormem na biodiversidade da nossa Amazônia.